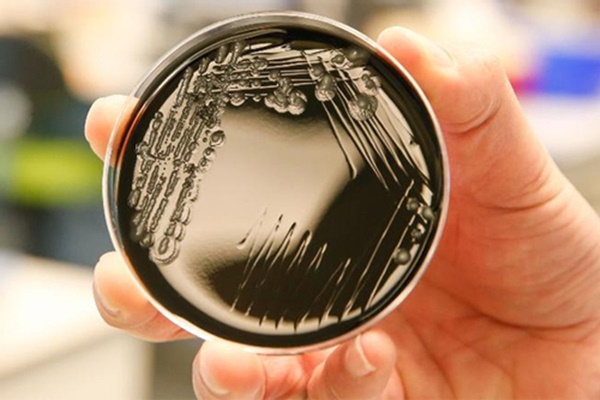
Bệnh nhân tử vong vì người nhà rút điện máy thở để... cắm điều hòa-2

Tờ Indian Express ngày 21-6 đưa tin một người đàn ông 40 tuổi đã qua đời tại bệnh viện Maharao Bhim Singh, bang Rajasthan sau khi người nhà ông này vô tình rút điện máy thở để dùng máy điều hòa không khí.
Trước đó, bệnh nhân bị nghi nhiễm Covid-19 và được đưa vào khu hồi sức tích cực (ICU) vào ngày 13-6. Tuy nhiên, kết quả xét nghiệm của ông này ra kết quả âm tính nên bệnh nhân được chuyển đến khu cách ly vào ngày 15-6 để đảm bảo an toàn sau khi một bệnh nhân khác trong khu ICU dương tính với Covid-19.
Do khu cách ly rất nóng nên gia đình bệnh nhân có mua một máy điều hòa ngay trong ngày 15-6. Vì không tìm thấy chỗ cắm điện, họ vô tình rút dây điện máy thở của bệnh nhân để dùng điều hòa. Máy thở tắt nguồn khoảng nửa tiếng sau đó sau khi dùng hết nguồn điện dự trữ.

Bệnh nhân tử vong vì người nhà rút điện máy thở để cắm điện điều hòa. Hình minh họa. Ảnh: Tribune India
Lúc này, người nhà mới lập tức thông báo cho bác sĩ và nhân viên y tế. Dù được thực hiện hồi sức tim phổi nhưng người đàn ông xấu số vẫn không qua khỏi. Giám đốc bệnh viện Naveen Saxena cho biết một ủy ban gồm phó giám đốc điều hành, giám đốc điều dưỡng và giám đốc y tế sẽ điều tra vụ việc và làm báo cáo.
Ủy ban đã ghi lại thông tin của các nhân viên y tế trong khu cách ly nhưng gia đình bệnh nhân lại tỏ ra không hợp tác. Bác sĩ Saxena khẳng định bất kỳ ai chịu trách nhiệm trong vụ việc sẽ bị xử lý.
Tuy nhiên, các quan chức bệnh viện khẳng định gia đình bệnh nhân đã không xin phép trước khi cắm điện điều hòa và khi bệnh nhân qua đời, họ còn có hành động gây rối với các nhân viên y tế và bác sĩ.
Theo NLD